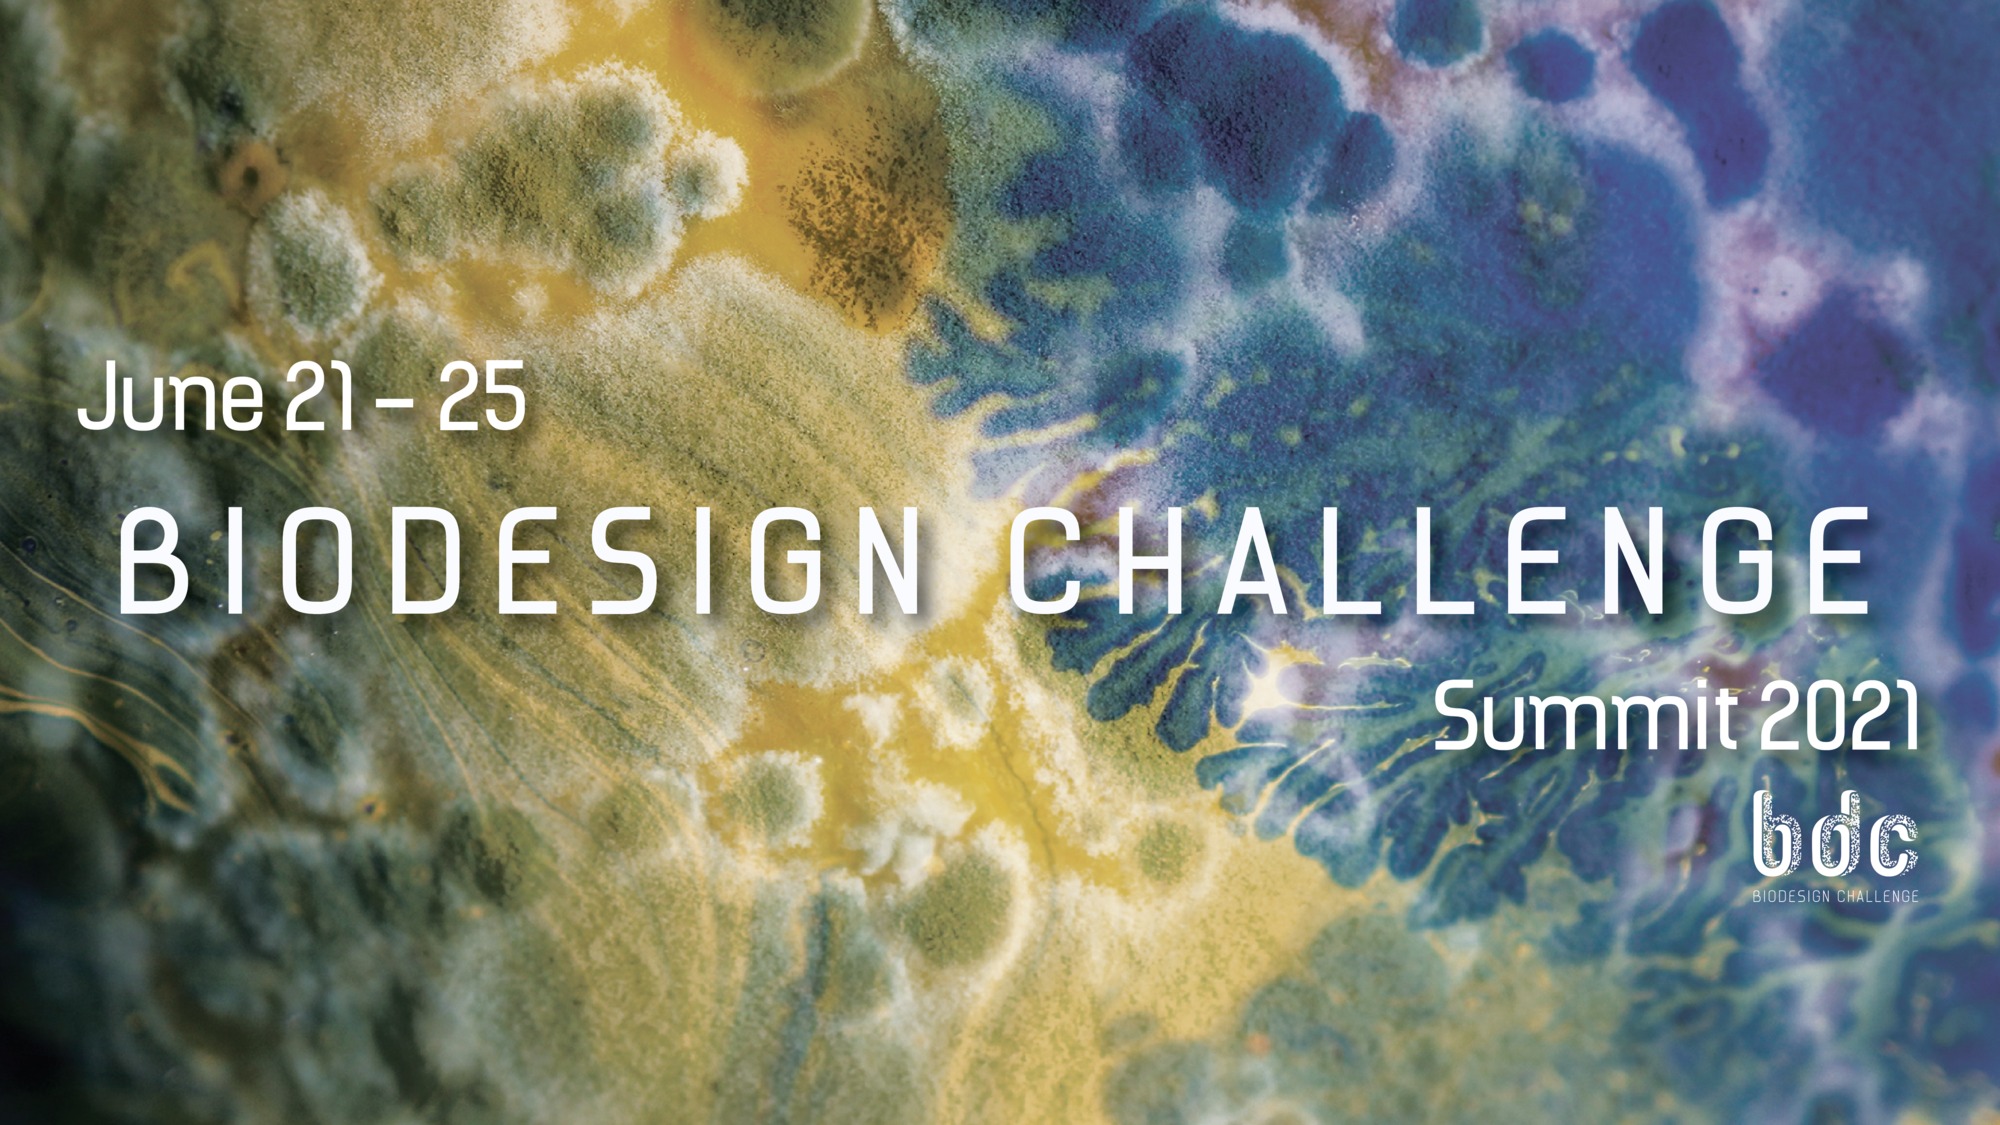
Biodesign Challenge Summit 2021 • Laura Splan

Bio Design Challenge 2018 Catalog
Bio Design Challenge 2018 Catalog - A good printable is one that understands its final purpose. gallon. 3D printing technology has even been used to create custom crochet hooks and accessories, blending the traditional with the cutting-edge. This shift was championed by the brilliant American statistician John Tukey. It might list the hourly wage of the garment worker, the number of safety incidents at the factory, the freedom of the workers to unionize. For most of human existence, design was synonymous with craft. Unboxing your Aura Smart Planter is an exciting moment, and we have taken great care to ensure that all the components are securely packaged. When we look at a catalog and decide to spend one hundred dollars on a new pair of shoes, the cost is not just the one hundred dollars. A signed physical contract often feels more solemn and binding than an email with a digital signature. The organizational chart, or "org chart," is a cornerstone of business strategy. Keeping your windshield washer fluid reservoir full will ensure you can maintain a clear view of the road in adverse weather. It has taken me from a place of dismissive ignorance to a place of deep respect and fascination. How does it feel in your hand? Is this button easy to reach? Is the flow from one screen to the next logical? The prototype answers questions that you can't even formulate in the abstract. The myth of the lone genius is perhaps the most damaging in the entire creative world, and it was another one I had to unlearn. Our brains are not naturally equipped to find patterns or meaning in a large table of numbers. The rise of new tools, particularly collaborative, vector-based interface design tools like Figma, has completely changed the game. The principles of motivation are universal, applying equally to a child working towards a reward on a chore chart and an adult tracking their progress on a fitness chart. The battery connector is a small, press-fit connector located on the main logic board, typically covered by a small metal bracket held in place by two Phillips screws. This offers the feel of a paper planner with digital benefits. Living in an age of burgeoning trade, industry, and national debt, Playfair was frustrated by the inability of dense tables of economic data to convey meaning to a wider audience of policymakers and the public. The variety of features and equipment available for your NISSAN may vary depending on the model, trim level, options selected, and region. Each sample, when examined with care, acts as a core sample drilled from the bedrock of its time. Educational posters displaying foundational concepts like the alphabet, numbers, shapes, and colors serve as constant visual aids that are particularly effective for visual learners, who are estimated to make up as much as 65% of the population. 47 Furthermore, the motivational principles of a chart can be directly applied to fitness goals through a progress or reward chart. These materials make learning more engaging for young children. For example, on a home renovation project chart, the "drywall installation" task is dependent on the "electrical wiring" task being finished first. This resilience, this ability to hold ideas loosely and to see the entire process as a journey of refinement rather than a single moment of genius, is what separates the amateur from the professional. 41 Different business structures call for different types of org charts, from a traditional hierarchical chart for top-down companies to a divisional chart for businesses organized by product lines, or a flat chart for smaller startups, showcasing the adaptability of this essential business chart. It ensures absolute consistency in the user interface, drastically speeds up the design and development process, and creates a shared language between designers and engineers. The genius lies in how the properties of these marks—their position, their length, their size, their colour, their shape—are systematically mapped to the values in the dataset. They understand that the feedback is not about them; it’s about the project’s goals. It seemed to be a tool for large, faceless corporations to stamp out any spark of individuality from their marketing materials, ensuring that every brochure and every social media post was as predictably bland as the last. You are prompted to review your progress more consciously and to prioritize what is truly important, as you cannot simply drag and drop an endless list of tasks from one day to the next. Extraneous elements—such as excessive gridlines, unnecessary decorations, or distracting 3D effects, often referred to as "chartjunk"—should be eliminated as they can obscure the information and clutter the visual field. This feeling is directly linked to our brain's reward system, which is governed by a neurotransmitter called dopamine. This means user research, interviews, surveys, and creating tools like user personas and journey maps. The modern, professional approach is to start with the user's problem. Here are some key benefits: Continuing Your Artistic Journey Spreadsheet Templates: Utilized in programs like Microsoft Excel and Google Sheets, these templates are perfect for financial planning, budgeting, project management, and data analysis. The Power of Writing It Down: Encoding and the Generation EffectThe simple act of putting pen to paper and writing down a goal on a chart has a profound psychological impact. Furthermore, our digital manuals are created with a clickable table of contents. If you only look at design for inspiration, your ideas will be insular. The studio would be minimalist, of course, with a single perfect plant in the corner and a huge monitor displaying some impossibly slick interface or a striking poster. In the digital realm, the nature of cost has become even more abstract and complex. It is a story. The layout is clean and grid-based, a clear descendant of the modernist catalogs that preceded it, but the tone is warm, friendly, and accessible, not cool and intellectual. A person can download printable artwork, from minimalist graphic designs to intricate illustrations, and instantly have an affordable way to decorate their home. And at the end of each week, they would draw their data on the back of a postcard and mail it to the other. My first encounter with a data visualization project was, predictably, a disaster. An incredible 90% of all information transmitted to the brain is visual, and it is processed up to 60,000 times faster than text. I had to define its clear space, the mandatory zone of exclusion around it to ensure it always had room to breathe and was never crowded by other elements. The job of the designer, as I now understand it, is to build the bridges between the two. How does a person move through a physical space? How does light and shadow make them feel? These same questions can be applied to designing a website. At first, it felt like I was spending an eternity defining rules for something so simple. Of course, there was the primary, full-color version. The most creative and productive I have ever been was for a project in my second year where the brief was, on the surface, absurdly restrictive. The idea of being handed a guide that dictated the exact hexadecimal code for blue I had to use, or the precise amount of white space to leave around a logo, felt like a creative straitjacket. This is the process of mapping data values onto visual attributes. Additionally, digital platforms can facilitate the sharing of journal entries with others, fostering a sense of community and support. They are the masters of this craft. The next frontier is the move beyond the screen. You are not bound by the layout of a store-bought planner. 35 Here, you can jot down subjective feelings, such as "felt strong today" or "was tired and struggled with the last set. The template is a distillation of experience and best practices, a reusable solution that liberates the user from the paralysis of the blank page and allows them to focus their energy on the unique and substantive aspects of their work. It depletes our finite reserves of willpower and mental energy. Once a story or an insight has been discovered through this exploratory process, the designer's role shifts from analyst to storyteller. This is the quiet, invisible, and world-changing power of the algorithm. While the scientific community and a vast majority of nations embraced its elegance and utility, the immense industrial and cultural inertia of the English-speaking world, particularly the United States, ensured the powerful persistence of the Imperial system. People display these quotes in their homes and offices for motivation. Finally, reinstall the two P2 pentalobe screws at the bottom of the device to secure the assembly. 4 However, when we interact with a printable chart, we add a second, powerful layer. Even with the most reliable vehicle, unexpected roadside emergencies can happen. That small, unassuming rectangle of white space became the primary gateway to the infinite shelf. This simple process bypasses traditional shipping and manufacturing. This is especially popular within the planner community. By planning your workout in advance on the chart, you eliminate the mental guesswork and can focus entirely on your performance. When a single, global style of furniture or fashion becomes dominant, countless local variations, developed over centuries, can be lost. We are drawn to symmetry, captivated by color, and comforted by texture. Building a quick, rough model of an app interface out of paper cutouts, or a physical product out of cardboard and tape, is not about presenting a finished concept.The Biodesign Challenge Seeding a Generation of Biodesigners to Shape
2018 Media Gallery — Biodesign Challenge
Biodesign Challenge Summit 2021 • Laura Splan
2018 in Review — Biodesign Challenge
2018 Media Gallery — Biodesign Challenge
2018 Media Gallery — Biodesign Challenge
University of Edinburgh 2018 — Biodesign Challenge
Biodesign Challenge Summit 2018 YouTube
Summit 2018 — Biodesign Challenge
Parsons 2018 — Biodesign Challenge
2018 Media Gallery — Biodesign Challenge
Summit 2022 — Biodesign Challenge
2018 Media Gallery — Biodesign Challenge
2018 Media Gallery — Biodesign Challenge
2018 Media Gallery — Biodesign Challenge
Parsons 2018 — Biodesign Challenge
2018 Media Gallery — Biodesign Challenge
Summit 2018 — Biodesign Challenge
2018 in Review — Biodesign Challenge
2018 Media Gallery — Biodesign Challenge
2018 Media Gallery — Biodesign Challenge
Biodesign Challenge Finalists HBBE
2018 Media Gallery — Biodesign Challenge
2018 Media Gallery — Biodesign Challenge
Press — Biodesign Challenge
Summit 2018 — Biodesign Challenge
2018 Media Gallery — Biodesign Challenge
2018 Media Gallery — Biodesign Challenge
2018 Media Gallery — Biodesign Challenge
BDC and HBBE Host Biodesign Symposium — Biodesign Challenge
CMU — Biodesign Challenge
Summit 2018 — Biodesign Challenge
2018 — Biodesign Challenge
2018 Media Gallery — Biodesign Challenge
Related Post: